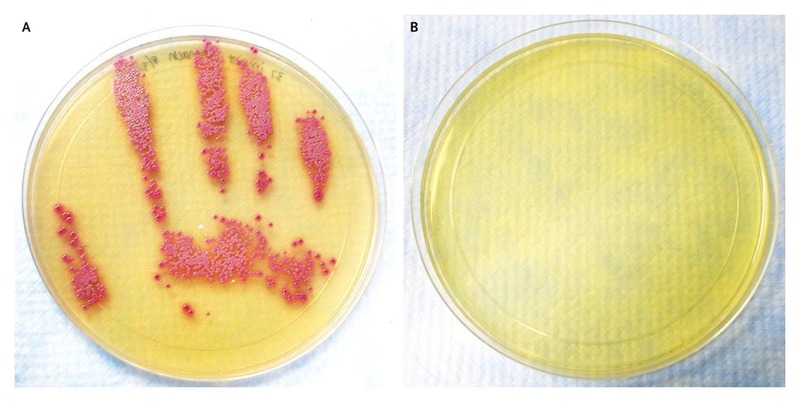

I listened to Reflections’ very own Martin Kiernan share his wisdom on the challenges around hand hygiene improvement this week, and thought I’d share my own reflections on his talk. The key point seemed to be that we have some way to go in winning the hearts and minds of our frontline clinical colleagues if we are to improve hand hygiene practice across the board.
Martin began with Semmelweis, as every good talk on hand hygiene should. The point being that Semmelweis had great data – a simple intervention to perform hand hygiene at a crucial moment slashed maternal mortality. But his intervention was not adopted during his lifetime. He failed to win the hearts and minds of his frontline clinical colleagues!
A good first step for meaningful hand hygiene improvement is getting real with audit data. We need to stop kidding ourselves with check-box auditing, and somehow get to accurate performance data so that we can identify areas that need more support. Automated monitoring of hand hygiene compliance is a promising new innovation – and will work best if coupled with individualised feedback. How would you feel if your personal hand hygiene compliance rate was the lowest during a shift??
One of the barriers often thrown up against hand hygiene is the lack of evidence that it’s effective in improving patient outcomes. And here’s Martin’s riposte:
- There are no RCTs showing that hand hygiene improves clinical patient outcomes. Then again, there are no RCTs showing that parachutes work. And there is overwhelming evidence from other study designs.
- Hands become extensively contaminated during patient care (in this study from way back in 1997, 17% of staff hand samples grew an outbreak strain of Klebsiella).
- Hand hygiene reduces the microbial burden on hands (see the lovely images in this NEJM article by Donskey and colleagues).
- If you don’t wash your hands, transmission of bacteria between patients occurs (in this shocking study from the 1960s, the parts of the unit where staff were specifically instructed not to wash their hands saw significantly more transmission of aureus – try getting this study design through an ethics committee…).
- There is convincing evidence that improving hand hygiene compliance results in fewer HCAIs (see the study by Pittet and colleagues in the Lancet).
- We compulsively touch our face way more than we think we do – so there’s a clear route between hand contamination and self-inoculation.
- False nails are a no no (linked to many outbreaks).
- There’s no specific evidence that being bare below the elbows improves patient outcomes per se – but it makes washing your hands easier – so why wouldn’t you?
- Encouraging patients to perform hand hygiene can improve patient outcomes (e.g. reduced SSI).
- There’s some important modelling work suggesting that improvements in hand hygiene compliance above the 65-70% mark make little impact in reducing transmission risk.
- All this data is nicely summarised in the WHO hand hygiene guidelines.
Figure: A hand print culture for MRSA following an abdominal examination of a patient colonised with MRSA before (A) and after (B) the use of an alcohol based hand hygiene product. From NEJM.
So why then in spite of all this evidence are levels of hand hygiene compliance so low (typically 40-50%)? A fundamental challenge is the delay between missed hand hygiene opportunities and subsequent transmission and infection. Wouldn’t it be great if a patient burst into flames whenever a hand hygiene opportunity was missed (well, not actually, but you see my point)! Another challenge is the way we go about hand hygiene promotion. ‘He who complies against his will is of his own opinion still’ so said Samuel Butler (1612-80). We can’t force staff to ‘comply’ with hand hygiene; compulsion may result in a short-term increase in compliance but it won’t win hearts and minds for sustained impact. Instead, we need to create the need for hand hygiene, ‘sell’ the evidence, and nudge staff who are already committed to keeping their patient safe towards effective hand hygiene.
Discover more from Reflections on Infection Prevention and Control
Subscribe to get the latest posts sent to your email.
I think the key point is the evidence tells us it is important but not how important. As a result an all consuming model like the five moments is promoted and this has no utility for busy clinical environments. Staff are totally committed but not to the nirvana policy of 100% compliance,
LikeLike